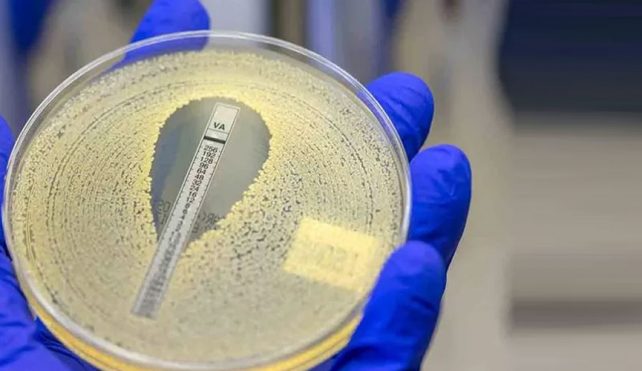

توریست مالزی
۱۸ بهمن ۱۴۰۰
توریست مالزی – پژوهشگران با انجام تجزیهوتحلیلی نشان دادند که پس از سکتهی مغزی و بیماری قلبی، عاملی موجب مرگومیر انسانها میشود که ممکن است به آن فکر نکنید.
به گزارش زومیت، مقاومت آنتیبیوتیکی اغلب بهعنوان مشکلی برای آینده در نظر گرفته میشود؛ اما دادههای تازهمنتشرشده نشان میدهد که این مشکل هماکنون بیش از تصور شما بر زندگی مردم اثر میگذارد. درواقع، برآوردهای جدید نشان میدهد که در سال ۲۰۱۹، ۴/۹۵ میلیون مرگ مرتبط با مقاومت ضدمیکروبی باکتریایی رخ داده است. بدینترتیب،، مقاومت ضدمیکروبی سومین علت اصلی مرگومیر در سراسر جهان است.
داروهایی که باکتریها را نابود میکنند، بیشک یکی از کشفهای بزرگ بشر هستند. از زمانی که الکساندر فلمینگ در سال ۱۹۲۸ فعالیت ضدباکتریایی را در قارچهای پنیسیلیوم کشف کرد، دیگر لازم نیست که نگران مرگ ناشی از خراشیدگیها یا سوزاک باشیم. در دهههای پسازآن، آنتیبیوتیکها جان میلیونها نفر را در سراسر جهان نجات دادهاند.
بااینهمه، باکتریها مدتها پیش از اینکه ما شروع به استفاده از آنتیبیوتیکها کنیم، در حال ایجاد مقاومت دربرابر آنها بودهاند؛ زیرا این ویژگی سلاح زیستی است که بهطور طبیعی برای جنگ بین میکروبها تکامل پیدا کرده است. استفاده مداوم از آنتیبیوتیک فرصتی برای باکتریها فراهم میکند تا سریعتر با آنها سازگار شوند و این امر به افزایش تعداد عفونتهایی منجر میشود که دیگر دربرابر آنتیبیوتیکهای معمول یا حتی آنتیبیوتیکهای استفادهشده بهعنوان آخرین چارهی درمانی واکنشی نشان نمیدهند.
متأسفانه هرچه گونههای باکتریایی بیشتری به آنتیبیوتیکها پاسخ ندهند، بیماران بیشتری تسلیم عفونتهای مقاوم میشوند. پژوهشگران هشدار میدهند که هماکنون تعداد افرادی که هر سال براثر مقاومت ضدمیکروبی جان خود را از دست میدهند، بیشتر از تعداد افرادی است که بهعلت اچآیوی (ایدز) یا مالاریا از دنیا میروند. کریس مورای، اقتصاددان بهداشت از دانشگاه واشینگتن و یکی از نویسندگان مطالعهی جدید میگوید:
دادههای جدید اندازهی حقیقی مقاومت ضدمیکروبی را در سراسر جهان نشان میدهند و سیگنال روشنی است که باید اکنون برای مبارزه با این تهدید اقدام کنیم. در برآوردهای گذشته، پیشبینی شده بود که در سال ۲۰۵۰، سالانه ۱۰ میلیون نفر براثر مقاومت ضدمیکروبی از دنیا میروند؛ اما اکنون مطمئنیم که درمقایسهبا چیزی که قبلاً تصور میکردیم، به این رقم نزدیکتریم. اگر میخواهیم در رقابت با مقاومت ضدمیکروبی جلو بیفتیم، باید از این دادهها برای اقدامات متناسب و هدایت نوآوری استفاده کنیم.
پژوهشگران دادههای مربوط به ۲۳ گونه مختلف باکتری، ازجمله اشریشیا کلی، استرپتوکوک پنومونیه و استافیلوکوکوس اورئوس و ۸۸ ترکیب میکروبدارو را از ۲۰۴ کشور تجزیهوتحلیل کردند. درنهایت، دادهها شامل ۴۷۱ میلیون رکورد عفونت شد که از آنها برای ایجاد مدلهای آماری بهمنظور برآورد اندازهی مقاومت ضدمیکروبی استفاده شد. پژوهشگران دو سناریو را بررسی کردند: ۱. تمام عفونتهای مقاوم به دارو با عفونتنداشتن جایگزین شدند که طبق توضیح پژوهشگران، تعداد مرگهای مرتبط با مقاومت ضدمیکروبی را نشان میدهد؛ ۲. آنها تمام عفونتهای مقاوم به دارو را با عفونتهای حساس به دارو جایگزین کردند که به برآوردی از مرگومیری منجر شد که مستقیماً ناشی از مقاومت ضدمیکروبی بود.
پژوهشگران بدیننتیجه رسیدند که در سال ۲۰۱۹، ۴/۹۵ میلیون مرگ با عفونتهای باکتریایی مقاوم به دارو مرتبط بوده است که از این میان، ۱/۲۷ میلیون مرگ مستقیما ناشی از مقاومت ضدمیکروبی بود. برایناساس، مقاومت ضدمیکروبی بار بزرگی است که تمام مناطق جهان، خصوصاً کشورهایی با درآمد کم و متوسط را تحتتأثیر قرار میدهد. محاسبات پژوهشگران نشان داد فقط سکتهی مغزی و بیماری قلبی درمقایسهبا مقاومت ضدمیکروبی، موجب مرگومیر بیشتری در آن سال شده بودند. نویسندگان میگویند تا جایی که میدانند، این اولینبار است که چنین برآورد جهانی انجام میشود.
ازآنجاکه دادههای برخی مناطق جهان ناقص است و مشکلات جدی در انجام نظارت بر مقاومت ضدمیکروبی وجود دارد، مدلسازی آنها محدودیتهایی دارد. بااینحال، نتیجهگیری واضح است: مشکل بهداشت عمومی جهانی بزرگی داریم.
مدتها است دربارهی مقاومت ضدمیکروبی هشدار داده شده است و همواره اقدامات موردنیاز، ازجمله افزایش آگاهی عمومی، نظارت بهتر، بهبود تشخیص، استفاده معقولتر از آنتیبیوتیکها، دسترسی به آب پاک و بهداشت و سرمایهگذاری روی واکسنها و ضدمیکروبهای جدید برای مقابله با مقاومت ضدمیکروبی توصیه شده است. سردبیران مجلهی لنست در سرمقالهای که همراه پژوهش جدید منتشر شده است، اضافه میکنند:
اقداماتی که در این زمینه انجام شده، غیرمنسجم و نابرابر بوده و این امر به ایجاد نابرابری جهانی در مقاومت ضدمیکروبی منجر شده است. نوآوری بسیار کُند بوده است. واکسنها فقط برای یک مورد از شش پاتوژن اصلی توصیفشده در مطالعه دردسترس هستند. خطتولید بالینی آنتیبیوتیکها برای مقابله با ظهور و گسترس مقاومت ضدمیکروبی بسیار کوچک است.
نویسندگان از رهبران میخواهند که به مقاومت ضدمیکروبی توجه بیشتری بکنند. آنان هشدار میدهند که بدون اقدام فوری، در سالهای پیش رو شاهد مرگومیر بیشتری خواهیم بود که البته پیشگیریکردنی است. این پژوهش در مجلهی The Lancet منتشر شده است.
به گزارش زومیت، مقاومت آنتیبیوتیکی اغلب بهعنوان مشکلی برای آینده در نظر گرفته میشود؛ اما دادههای تازهمنتشرشده نشان میدهد که این مشکل هماکنون بیش از تصور شما بر زندگی مردم اثر میگذارد. درواقع، برآوردهای جدید نشان میدهد که در سال ۲۰۱۹، ۴/۹۵ میلیون مرگ مرتبط با مقاومت ضدمیکروبی باکتریایی رخ داده است. بدینترتیب،، مقاومت ضدمیکروبی سومین علت اصلی مرگومیر در سراسر جهان است.
داروهایی که باکتریها را نابود میکنند، بیشک یکی از کشفهای بزرگ بشر هستند. از زمانی که الکساندر فلمینگ در سال ۱۹۲۸ فعالیت ضدباکتریایی را در قارچهای پنیسیلیوم کشف کرد، دیگر لازم نیست که نگران مرگ ناشی از خراشیدگیها یا سوزاک باشیم. در دهههای پسازآن، آنتیبیوتیکها جان میلیونها نفر را در سراسر جهان نجات دادهاند.
بااینهمه، باکتریها مدتها پیش از اینکه ما شروع به استفاده از آنتیبیوتیکها کنیم، در حال ایجاد مقاومت دربرابر آنها بودهاند؛ زیرا این ویژگی سلاح زیستی است که بهطور طبیعی برای جنگ بین میکروبها تکامل پیدا کرده است. استفاده مداوم از آنتیبیوتیک فرصتی برای باکتریها فراهم میکند تا سریعتر با آنها سازگار شوند و این امر به افزایش تعداد عفونتهایی منجر میشود که دیگر دربرابر آنتیبیوتیکهای معمول یا حتی آنتیبیوتیکهای استفادهشده بهعنوان آخرین چارهی درمانی واکنشی نشان نمیدهند.
متأسفانه هرچه گونههای باکتریایی بیشتری به آنتیبیوتیکها پاسخ ندهند، بیماران بیشتری تسلیم عفونتهای مقاوم میشوند. پژوهشگران هشدار میدهند که هماکنون تعداد افرادی که هر سال براثر مقاومت ضدمیکروبی جان خود را از دست میدهند، بیشتر از تعداد افرادی است که بهعلت اچآیوی (ایدز) یا مالاریا از دنیا میروند. کریس مورای، اقتصاددان بهداشت از دانشگاه واشینگتن و یکی از نویسندگان مطالعهی جدید میگوید:
دادههای جدید اندازهی حقیقی مقاومت ضدمیکروبی را در سراسر جهان نشان میدهند و سیگنال روشنی است که باید اکنون برای مبارزه با این تهدید اقدام کنیم. در برآوردهای گذشته، پیشبینی شده بود که در سال ۲۰۵۰، سالانه ۱۰ میلیون نفر براثر مقاومت ضدمیکروبی از دنیا میروند؛ اما اکنون مطمئنیم که درمقایسهبا چیزی که قبلاً تصور میکردیم، به این رقم نزدیکتریم. اگر میخواهیم در رقابت با مقاومت ضدمیکروبی جلو بیفتیم، باید از این دادهها برای اقدامات متناسب و هدایت نوآوری استفاده کنیم.
پژوهشگران دادههای مربوط به ۲۳ گونه مختلف باکتری، ازجمله اشریشیا کلی، استرپتوکوک پنومونیه و استافیلوکوکوس اورئوس و ۸۸ ترکیب میکروبدارو را از ۲۰۴ کشور تجزیهوتحلیل کردند. درنهایت، دادهها شامل ۴۷۱ میلیون رکورد عفونت شد که از آنها برای ایجاد مدلهای آماری بهمنظور برآورد اندازهی مقاومت ضدمیکروبی استفاده شد. پژوهشگران دو سناریو را بررسی کردند: ۱. تمام عفونتهای مقاوم به دارو با عفونتنداشتن جایگزین شدند که طبق توضیح پژوهشگران، تعداد مرگهای مرتبط با مقاومت ضدمیکروبی را نشان میدهد؛ ۲. آنها تمام عفونتهای مقاوم به دارو را با عفونتهای حساس به دارو جایگزین کردند که به برآوردی از مرگومیری منجر شد که مستقیماً ناشی از مقاومت ضدمیکروبی بود.
پژوهشگران بدیننتیجه رسیدند که در سال ۲۰۱۹، ۴/۹۵ میلیون مرگ با عفونتهای باکتریایی مقاوم به دارو مرتبط بوده است که از این میان، ۱/۲۷ میلیون مرگ مستقیما ناشی از مقاومت ضدمیکروبی بود. برایناساس، مقاومت ضدمیکروبی بار بزرگی است که تمام مناطق جهان، خصوصاً کشورهایی با درآمد کم و متوسط را تحتتأثیر قرار میدهد. محاسبات پژوهشگران نشان داد فقط سکتهی مغزی و بیماری قلبی درمقایسهبا مقاومت ضدمیکروبی، موجب مرگومیر بیشتری در آن سال شده بودند. نویسندگان میگویند تا جایی که میدانند، این اولینبار است که چنین برآورد جهانی انجام میشود.
ازآنجاکه دادههای برخی مناطق جهان ناقص است و مشکلات جدی در انجام نظارت بر مقاومت ضدمیکروبی وجود دارد، مدلسازی آنها محدودیتهایی دارد. بااینحال، نتیجهگیری واضح است: مشکل بهداشت عمومی جهانی بزرگی داریم.
مدتها است دربارهی مقاومت ضدمیکروبی هشدار داده شده است و همواره اقدامات موردنیاز، ازجمله افزایش آگاهی عمومی، نظارت بهتر، بهبود تشخیص، استفاده معقولتر از آنتیبیوتیکها، دسترسی به آب پاک و بهداشت و سرمایهگذاری روی واکسنها و ضدمیکروبهای جدید برای مقابله با مقاومت ضدمیکروبی توصیه شده است. سردبیران مجلهی لنست در سرمقالهای که همراه پژوهش جدید منتشر شده است، اضافه میکنند:
اقداماتی که در این زمینه انجام شده، غیرمنسجم و نابرابر بوده و این امر به ایجاد نابرابری جهانی در مقاومت ضدمیکروبی منجر شده است. نوآوری بسیار کُند بوده است. واکسنها فقط برای یک مورد از شش پاتوژن اصلی توصیفشده در مطالعه دردسترس هستند. خطتولید بالینی آنتیبیوتیکها برای مقابله با ظهور و گسترس مقاومت ضدمیکروبی بسیار کوچک است.
نویسندگان از رهبران میخواهند که به مقاومت ضدمیکروبی توجه بیشتری بکنند. آنان هشدار میدهند که بدون اقدام فوری، در سالهای پیش رو شاهد مرگومیر بیشتری خواهیم بود که البته پیشگیریکردنی است. این پژوهش در مجلهی The Lancet منتشر شده است.